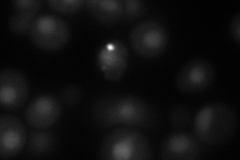
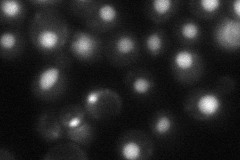
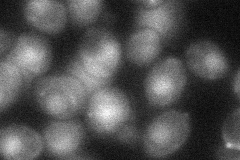

View description
Subunit of heteropentameric Replication factor C (RF-C), which is a DNA binding protein and ATPase that acts as a clamp loader of the proliferating cell nuclear antigen (PCNA) processivity factor for DNA polymerases delta and epsilon
Localization:
Intensity:
Fold change:
Significance:
-
C’ GFP library in SD

nucleus28.31 -
N' NOP1pr-GFP in SD

nucleus92.0336 -
N' TEF2pr-mCherry in SD
nucleus51.5008 -
N' NATIVEpr-GFP in SD
nucleus52.9408 -
N' TEF2pr-VC and Cyto-VN in SD
nucleus38.2877 -
C’ GFP library in SD+DTT

nucleusN/AN/AYes -
C’ GFP library in SD+H2O2

nucleusN/AN/ANo -
C’ GFP library in Starvation Media

nucleusN/AN/AYes -
C’ GFP library on the background of Pup2-DaMP

N/A -
C’ GFP library on the background of CCT mutant

N/A0N/AYes
